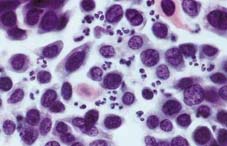
什么是慢性肾脏病 当心不知不觉的肾损伤

北京大学第一医院杨莉:急性肾损伤的防治
本期访谈内容包括:什么是急性肾损伤,急性肾损伤的表症和自我诊断,急性肾损伤易得人群及早期预防,哪些药物会引起急性肾损伤,早期发现急性肾损伤的方法,确诊急性肾损伤后如何治疗,急性肾脏病与慢性肾脏病的关系。 [详细]
中西医结合辩证施治“急性肾损伤”
中医很早就有经典明确记录了急性肾损伤(AKI)临床表现、发病机制,如《伤害杂病论》 [详细]
- 上海肾小球肾炎患者八成年轻人 03-14
- 连服多种感冒药招来急性肾损伤 03-14
- 近三成截肢祸起糖尿病 01-16
- 含西药成分的中成药或成重大用药隐患 03-12
- 老年人和糖尿病患者等成急性肾损伤高发人群 03-14
- 雾霾天肾病患者防咽肺感染 03-13
- 半年喝1500瓶饮料 男孩突患原发性肾病 03-13
专家访谈
李建民:中西医结合施治“急性肾损伤”
急性肾损伤为现代医学诊断,中医学将其归于水肿、癃闭、关格、肾风、溺毒、虚劳等范畴。 [详细]
刘志红:急性肾损伤防治应城乡有别
急性肾损伤不仅导致高死亡率,还与慢性肾脏病的发生发展密切相关,构成肾脏疾病高发和快速进展的恶性循环。 [详细]
急性肾损伤易得人群及早期预防
最常见的器官损伤就是肾脏损伤。导致急性肾损伤的原因主要是两类,一类叫缺血性肾损伤;一类叫毒性肾损伤。 [详细]